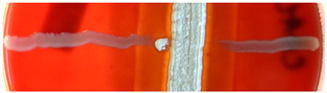
Ijms 23 15045 i002 Ijms 23 15045 i002
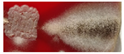
Ijms 23 15045 i020 Ijms 23 15045 i020
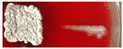
Ijms 23 15045 i027 Ijms 23 15045 i027
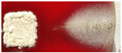
Ijms 23 15045 i045 Ijms 23 15045 i045
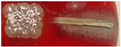
Ijms 23 15045 i049 Ijms 23 15045 i049
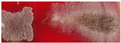
Ijms 23 15045 i055 Ijms 23 15045 i055
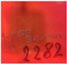
Ijms 23 15045 i056 Ijms 23 15045 i056
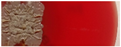
Ijms 23 15045 i057 Ijms 23 15045 i057

Polyenic Antibiotics and Other Antifungal Compounds Produced by Hemolytic Streptomyces Species
Abstract
1. Introduction
1.1. The Role of Hemolysis in Streptomyces’ Interactions
1.2. Polyenes and Non-Polyene Hemolytic Metabolites: A Literature Review
1.3. Hemolysis as a Virulence Factor
2. Results
2.1. Sequencing Data and Phylogenetic Tree
2.2. Characteristics of Morphological Differentiation and Hemolytic Activities in the Strains
2.3. Gamma-Butyrolactone-Induced Polyene Production
2.4. Hemolytic Activity of Ethyl Acetate Extracts
2.5. LC-MS Analysis of the Supernatant Extracts
2.6. Selected Hemolytic Activity Is Likely Not Due to Lytic Proteins

2.7. Hemolytic Compounds Identified in Paired Co-Cultures
2.8. Inhibitory Activity of Streptomyces against Candida albicans or Filamentous Fungi
3. Discussion
4. Materials and Methods
4.1. Strains
4.2. 16S rRNA-encoding Gene-Based Phylogeny
4.3. Culture Media and Cultivation Conditions
4.4. Ethyl Acetate Extraction and Hemolytic Activity Testing
4.5. Solid-Phase Extraction
4.6. LC-MS Analysis
4.7. Testing for the Presence of Extracellular Hemolytic Proteins
4.8. Antifungal Activity of Streptomyces
5. Conclusions
Supplementary Materials
Author Contributions
Funding
Institutional Review Board Statement
Informed Consent Statement
Data Availability Statement
Acknowledgments
Conflicts of Interest
References
- Procopio, R.E.; Silva, I.R.; Martins, M.K.; Azevedo, J.L.; Araujo, J.M. Antibiotics produced by streptomyces. Braz. J. Infect. Dis. 2012, 16, 466–471. [Google Scholar] [CrossRef] [PubMed]
- Gross, H. Strategies to unravel the function of orphan biosynthesis pathways: Recent examples and future prospects. Appl. Microbiol. Biotechnol. 2007, 75, 267–277. [Google Scholar] [CrossRef] [PubMed]
- Wanner, L.A. A new strain of streptomyces causing common scab in potato. Plant. Dis. 2007, 91, 352–359. [Google Scholar] [CrossRef] [PubMed]
- el Hassan, A.M.; Fahal, A.H.; Ahmed, A.O.; Ismail, A.; Veress, B. The immunopathology of actinomycetoma lesions caused by streptomyces somaliensis. Trans. R. Soc. Trop. Med. Hyg. 2001, 95, 89–92. [Google Scholar] [CrossRef]
- Seipke, R.F.; Kaltenpoth, M.; Hutchings, M.I. Streptomyces as symbionts: An emerging and widespread theme? FEMS Microbiol. Rev. 2012, 36, 862–876. [Google Scholar] [CrossRef]
- Zhang, X.H.; Austin, B. Haemolysins in vibrio species. J. Appl. Microbiol. 2005, 98, 1011–1019. [Google Scholar] [CrossRef]
- Vesper, S.J.; Vesper, M.J. Possible role of fungal hemolysins in sick building syndrome. Adv. Appl. Microbiol. 2004, 55, 191–213. [Google Scholar]
- Bhakdi, S.; Tranum-Jensen, J. Complement lysis: A hole is a hole. Immunol. Today 1991, 12, 318–320; discussion 321. [Google Scholar] [CrossRef]
- Dixon, D.M.; Walsh, T.J. Antifungal agents. In Medical. Microbiology; Baron, S., Ed.; University of Texas Medical Branch at Galveston: Galveston, TX, USA, 1996. [Google Scholar]
- Dinos, G.P. The macrolide antibiotic renaissance. Br. J. Pharmacol. 2017, 174, 2967–2983. [Google Scholar] [CrossRef]
- Kristanc, L.; Bozic, B.; Jokhadar, S.Z.; Dolenc, M.S.; Gomiscek, G. The pore-forming action of polyenes: From model membranes to living organisms. Biochim. Biophys. Acta Biomembr. 2019, 1861, 418–430. [Google Scholar] [CrossRef]
- Guo, X.; Zhang, J.; Li, X.; Xiao, E.; Lange, J.D.; Rienstra, C.M.; Burke, M.D.; Mitchell, D.A. Sterol sponge mechanism is conserved for glycosylated polyene macrolides. ACS Cent. Sci. 2021, 7, 781–791. [Google Scholar] [CrossRef] [PubMed]
- Trejo, W.H.; Bennett, R.E. Streptomyces nodosus sp. N., the amphotericin-producing organism. J. Bacteriol. 1963, 85, 436–439. [Google Scholar] [CrossRef] [PubMed]
- Xiong, Z.Q.; Tu, X.R.; Wei, S.J.; Huang, L.; Li, X.H.; Lu, H.; Tu, G.Q. The mechanism of antifungal action of a new polyene macrolide antibiotic antifungalmycin 702 from streptomyces padanus jau4234 on the rice sheath blight pathogen rhizoctonia solani. PLoS ONE 2013, 8, e73884. [Google Scholar] [CrossRef]
- Shenin, I.; Solov’ev, V.N.; Nvinskii, A.A. [structure of the polyenic antibiotic, arenomycin b]. Antibiotiki 1973, 18, 872–876. [Google Scholar]
- Yang, J.; Xu, D.; Yu, W.; Hao, R.; Wei, J. Regulation of aureofuscin production by the PAS-LuxR family regulator AurJ3M. Enzym. Microb. Technol. 2020, 137, 109532. [Google Scholar] [CrossRef]
- Graessle, O.E.; Phares, H.F.; Robinson, H.J. In vitro studies with a new antimycotic agent: Lucensomycin. Antibiot Chemother 1962, 12, 608–617. [Google Scholar]
- Kim, H.J.; Kim, M.K.; Lee, M.J.; Won, H.J.; Choi, S.S.; Kim, E.S. Post-pks tailoring steps of a disaccharide-containing polyene npp in pseudonocardia autotrophica. PLoS ONE 2015, 10, e0123270. [Google Scholar] [CrossRef]
- Hazen, E.L.; Brown, R. Fungicidin, an antibiotic produced by a soil actinomycete. Proc. Soc. Exp. Biol. Med. 1951, 76, 93–97. [Google Scholar] [CrossRef] [PubMed]
- Struyk, A.P.; Hoette, I.; Drost, G.; Waisvisz, J.M.; Van Eek, T.; Hoogerheide, J.C. Pimaricin, a new antifungal antibiotic. Antibiot Annu. 1957, 5, 878–885. [Google Scholar]
- Ulrych, A.; Derrick, P.J.; Adamek, F.; Novak, P.; Lemr, K.; Havlicek, V. Dissociation of nystatin and amphotericin analogues: Characterisation of minor anti-fungal macrolides. Eur. J. Mass. Spectrom. 2010, 16, 73–80. [Google Scholar] [CrossRef]
- Hamilton-Miller, J.M. Chemistry and biology of the polyene macrolide antibiotics. Bacteriol. Rev. 1973, 37, 166–196. [Google Scholar] [CrossRef] [PubMed]
- Davisson, J.W.; Tanner, F.W., Jr.; Finlay, A.C.; Solomons, I.A. Rimocidin, a new antibiotic. Antibiot Chemother 1951, 1, 289–290. [Google Scholar] [PubMed]
- Veiga, M.; Fabregas, J. Tetrafungin, a new polyene macrolide antibiotic. I. Fermentation, isolation, characterization, and biological properties. J. Antibiot. 1983, 36, 770–775. [Google Scholar] [CrossRef] [PubMed]
- Dornberger, K.; Fugner, R.; Bradler, G.; Thrum, H. Tetramycin, a new polyene antibiotic. J. Antibiot. 1971, 24, 172–177. [Google Scholar] [CrossRef]
- Pandey, R.C.; German, V.F.; Nishikawa, Y.; Rinehart, K.L., Jr. Polyene antibiotics. Ii. The strucutre of tetrin a. J. Am. Chem. Soc. 1971, 93, 3738–3747. [Google Scholar]
- Ryu, G.; Choi, W.C.; Hwang, S.; Yeo, W.H.; Lee, C.S.; Kim, S.K. Tetrin c, a new glycosylated polyene macrolide antibiotic produced by streptomyces sp. Gk9244. J. Nat. Prod. 1999, 62, 917–919. [Google Scholar] [CrossRef]
- English, A.R.; Mc, B.T. Pa 150, pa 153, and pa 166: New polyene antifungal antibiotics: Biological studies. Antibiot Annu. 1957, 5, 893–896. [Google Scholar]
- Taig, M.M.; Solov’eva, N.K.; Braginskaia, P.S. [characteristics of the culture-producer of aurenin]. Antibiotiki 1969, 14, 873–876. [Google Scholar] [PubMed]
- Caltrider, P.; Gottlieb, D. Capacidin: A new member of the polyene antibiotic group. Antibiot Chemother 1961, 10, 702–708. [Google Scholar]
- Pandey, R.C.; Narasimhachari, N.; Rinehart, K.L., Jr.; Millington, D.S. Polyene antibiotics. Iv. Structure of chainin. J. Am. Chem. Soc. 1972, 94, 4306–4310. [Google Scholar] [CrossRef]
- Trinci, A.; Chalkley, L.J. Comparison of the effects of the polyenes amphotericin b and elizabethin on candida pseudotropicalis. Trans. Br. Mycol. Soc. 1983, 80, 491–495. [Google Scholar] [CrossRef]
- Cirillo, V.P.; Harsch, M.; Lampen, J.O. Action of the polyene antibiotics filipin, nystatin and n-acetylcandidin on the yeast cell membrane. J. Gen. Microbiol. 1964, 35, 249–259. [Google Scholar] [CrossRef] [PubMed]
- Umezawa, S.; Tanaka, Y.; Ooka, M.; Shiotsu, S. A new antifungal antibiotic, pentamycin. J. Antibiot. 1958, 11, 26–29. [Google Scholar] [PubMed]
- Li, Z.; Rawlings, B.J.; Harrison, P.H.; Vederas, J.C. Production of new polyene antibiotics by streptomyces cellulosae after addition of ethyl (z)-16-phenylhexadec-9-enoate. J. Antibiot. 1989, 42, 577–584. [Google Scholar] [CrossRef] [PubMed]
- Endo, M.; Hayashida, T.; Tsunematsu, Y. [application of an antifungal antibiotic (kabicidin) in cultures of cells]. Jpn. J. Med. Sci. Biol. 1959, 12, 173–174. [Google Scholar] [CrossRef] [PubMed][Green Version]
- Brazhnikova, M.G.; Kudinova, M.K.; Lavrova, M.F.; Borisova, V.N.; Krugliak, E.B. [isolation, purification and physico-chemical properties of antibiotic lienomycin]. Antibiotiki 1971, 16, 483–486. [Google Scholar] [PubMed]
- Bycroft, B.W.; Payne, D.J. Dictionary of Antibiotics and Related Substances: With CD-ROM, 2nd ed.; CRC Press: Boca Raton, FL, USA, 2014. [Google Scholar]
- Berdy, J.; Horváth, I. Antibiotics produced by streptomyces vi. Pentafungin, a new antifungal antibiotic. J. Basic Microbiol. 2007, 5, 345–350. [Google Scholar]
- Yao, T.; Liu, Z.; Li, T.; Zhang, H.; Liu, J.; Li, H.; Che, Q.; Zhu, T.; Li, D.; Li, W. Characterization of the biosynthetic gene cluster of the polyene macrolide antibiotic reedsmycins from a marine-derived streptomyces strain. Microb. Cell Fact 2018, 17, 98. [Google Scholar] [CrossRef]
- Van Arnam, E.B.; Ruzzini, A.C.; Sit, C.S.; Horn, H.; Pinto-Tomas, A.A.; Currie, C.R.; Clardy, J. Selvamicin, an atypical antifungal polyene from two alternative genomic contexts. Proc. Natl. Acad. Sci. USA 2016, 113, 12940–12945. [Google Scholar] [CrossRef]
- Guo, J.; Schlingmann, G.; Carter, G.T.; Nakanishi, K.; Berova, N. Absolute stereochemistry of the strevertenes. Chirality 2000, 12, 43–51. [Google Scholar] [CrossRef]
- Kim, Y.P.; Tomoda, H.; Iizima, K.; Fukuda, T.; Matsumoto, A.; Takahashi, Y.; Omura, S. Takanawaenes, novel antifungal antibiotics produced by streptomyces sp. K99-5278. I. Taxonomy, fermentation, isolation and biological properties. J. Antibiot. 2003, 56, 448–453. [Google Scholar] [CrossRef] [PubMed][Green Version]
- Greule, A.; Intra, B.; Flemming, S.; Rommel, M.G.; Panbangred, W.; Bechthold, A. The draft genome sequence of actinokineospora bangkokensis 44ehw(t) reveals the biosynthetic pathway of the antifungal thailandin compounds with unusual butylmalonyl-coa extender units. Molecules 2016, 21, 1607. [Google Scholar] [CrossRef] [PubMed]
- Martin, J.F.; McDaniel, L.E. Isolation, purification and properties of the hexaene macrolides candihexin i and candihexin ii. J. Antibiot. 1974, 27, 610–619. [Google Scholar] [CrossRef] [PubMed]
- Sakamoto, J.M. [study on antifungal antibiotics. Ii. Cryptocidin, a new antibiotic produced by streptomycetes]. J. Antibiot. 1959, 12, 21–23. [Google Scholar]
- Barashkova, N.P.; Shenin Iu, D.; Omel’chenko, V.N.; Konev Iu, E. [actinomyces chromogenes var. Graecus var. Nov., a producer of a new hexaene antibiotic]. Antibiotiki 1977, 22, 832–837. [Google Scholar]
- Chakrabarti, S.; Chandra, A.L. A new streptomycete and a new polyene antibiotic, acmycin. Folia Microbiol. (Praha) 1982, 27, 167–172. [Google Scholar] [CrossRef]
- Dutcher, J.D. The discovery and development of amphotericin b. Dis. Chest 1968, 54 (Suppl. S1), 296–298. [Google Scholar] [CrossRef]
- Kotler-Brajtburg, J.; Medoff, G.; Kobayashi, G.S.; Boggs, S.; Schlessinger, D.; Pandey, R.C.; Rinehart, K.L., Jr. Classification of polyene antibiotics according to chemical structure and biological effects. Antimicrob. Agents Chemother. 1979, 15, 716–722. [Google Scholar] [CrossRef]
- Kligman, A.M.; Lewis, F.S. In vitro and in vivo activity of candicidin on pathogenic fungi. Proc. Soc. Exp. Biol. Med. 1953, 82, 399–404. [Google Scholar] [CrossRef]
- Taber, W.A.; Vining, L.C.; Waksman, S.A. Candidin, a new antifungal antibiotic produced by streptomyces viridoflavus. Antibiot Chemother 1954, 4, 455–461. [Google Scholar]
- Kruglikova, L.F.; Shenin Iu, D. [characteristics of a new aromatic heptaenic antibiotic, flavumycin a]. Antibiotiki 1976, 21, 407–411. [Google Scholar] [PubMed]
- Mohan, R.R.; Pianotti, R.S.; Martin, J.F.; Ringel, S.M.; Schwartz, B.S.; Bailey, E.G.; McDaniel, L.E.; Schaffner, C.P. Fungimycin production, isolation, biosynthesis, and in vitro antifungal activity. Antimicrob. Agents Chemother. 1963, 161, 462–470. [Google Scholar] [PubMed]
- Gokhale, B.B. Hamycin--A new antifungal antibiotic. Arch. Dermatol. 1963, 88, 558–560. [Google Scholar] [CrossRef] [PubMed]
- Filippova, A.I.; Solov’ev, S.N.; Vasil’eva, N.G.; Dumova, A.M.; Egorenkova, A.N. [isomerization of polyene antibiotics with characteristics of isolevorin a2]. Antibiotiki 1972, 17, 932–937. [Google Scholar]
- Filippova, A.I.; Lashkov, G.I.; Kozel, S.P.; Shenin Iu, D. [spectrophotometric research on the photochemical isomerization of the polyene macrolide antibiotic levorin a2]. Antibiot Med. Biotekhnol. 1987, 32, 749–754. [Google Scholar]
- Borowski, E.; Malyshkina, M.; Soloviev, S.; Ziminski, T. Isolation and characterization of levorin a and b, the heptaene macrolide antifungal antibiotics of “aromatic” subgroup. Chemotherapy 1965, 10, 176–194. [Google Scholar] [CrossRef]
- Martinez-Quesada, J.; Torres-Rodriguez, J.M.; Roses-Codinachs, M.; Amaral-Olivera, M. Minimal inhibitory concentrations of lucknomycin, a new polyenic derivative, for candida and aspergillus spp. Antimicrob. Agents Chemother. 1983, 24, 132–133. [Google Scholar] [CrossRef]
- Luna, T.; Mazzolla, R.; Romano, G.; Blasi, E. Potent antifungal effects of a new derivative of partricin a in a murine model of cerebral cryptococcosis. Antimicrob. Agents Chemother. 1997, 41, 706–708. [Google Scholar] [CrossRef]
- Pawlak, J.; Sowinski, P.; Borowski, E.; Gariboldi, P. Stereostructure of perimycin a. J. Antibiot. 1995, 48, 1034–1038. [Google Scholar] [CrossRef][Green Version]
- Mendizabal, A.F.; Inza, R.; Salaber, J.A. [trichomycin: A new antibiotic for the treatment of colpitis caused by trichomonas & candida albicans]. Rev. Asoc. Med. Argent. 1957, 71, 48–50. [Google Scholar]
- Bortolo, R.; Spera, S.; Gugliemetti, G.; Cassani, G. Ab023, novel polyene antibiotics. Ii. Isolation and structure determination. J. Antibiot. 1993, 46, 255–264. [Google Scholar] [CrossRef] [PubMed][Green Version]
- Cai, P.; Kong, F.; Fink, P.; Ruppen, M.E.; Williamson, R.T.; Keiko, T. Polyene antibiotics from streptomyces mediocidicus. J. Nat. Prod. 2007, 70, 215–219. [Google Scholar] [CrossRef] [PubMed]
- McAlpine, J.B.; Bachmann, B.O.; Piraee, M.; Tremblay, S.; Alarco, A.M.; Zazopoulos, E.; Farnet, C.M. Microbial genomics as a guide to drug discovery and structural elucidation: Eco-02301, a novel antifungal agent, as an example. J. Nat. Prod. 2005, 68, 493–496. [Google Scholar] [CrossRef] [PubMed]
- Irschik, H.; Schummer, D.; Hofle, G.; Reichenbach, H.; Steinmetz, H.; Jansen, R. Etnangien, a macrolide-polyene antibiotic from sorangium cellulosum that inhibits nucleic acid polymerases. J. Nat. Prod. 2007, 70, 1060–1063. [Google Scholar] [CrossRef]
- Park, H.S.; Nah, H.J.; Kang, S.H.; Choi, S.S.; Kim, E.S. Screening and isolation of a novel polyene-producing streptomyces strain inhibiting phytopathogenic fungi in the soil environment. Front. Bioeng. Biotechnol. 2021, 9, 692340. [Google Scholar] [CrossRef] [PubMed]
- Almeida, E.L.; Kaur, N.; Jennings, L.K.; Carrillo Rincon, A.F.; Jackson, S.A.; Thomas, O.P.; Dobson, A.D.W. Genome mining coupled with osmac-based cultivation reveal differential production of surugamide a by the marine sponge isolate streptomyces sp. Sm17 when compared to its terrestrial relative s. Albidoflavus j1074. Microorganisms 2019, 7, 394. [Google Scholar] [CrossRef]
- Chater, K.F.; Biro, S.; Lee, K.J.; Palmer, T.; Schrempf, H. The complex extracellular biology of streptomyces. FEMS Microbiol. Rev. 2010, 34, 171–198. [Google Scholar] [CrossRef]
- Matsuda, K.; Kuranaga, T.; Sano, A.; Ninomiya, A.; Takada, K.; Wakimoto, T. The revised structure of the cyclic octapeptide surugamide a. Chem. Pharm. Bull. 2019, 67, 476–480. [Google Scholar] [CrossRef]
- Umezawa, K.; Nakazawa, K.; Ikeda, Y.; Naganawa, H.; Kondo, S. Polyoxypeptins a and b produced by streptomyces: Apoptosis-inducing cyclic depsipeptides containing the novel amino acid (2s,3r)-3-hydroxy-3-methylproline. J. Org. Chem. 1999, 64, 3034–3038. [Google Scholar] [CrossRef]
- Umezawa, H. Bleomycin and other antitumor antibiotics of high molecular weight. Antimicrob. Agents Chemother. (Bethesda) 1965, 5, 1079–1085. [Google Scholar]
- Johnson, A.W. The chemistry of actinomycin d and related compounds. Ann. N. Y. Acad. Sci. 1960, 89, 336–341. [Google Scholar] [CrossRef] [PubMed]
- Giessen, T.W.; Franke, K.B.; Knappe, T.A.; Kraas, F.I.; Bosello, M.; Xie, X.; Linne, U.; Marahiel, M.A. Isolation, structure elucidation, and biosynthesis of an unusual hydroxamic acid ester-containing siderophore from actinosynnema mirum. J. Nat. Prod. 2012, 75, 905–914. [Google Scholar] [CrossRef] [PubMed]
- Kido, G.S.; Spyhalski, E. Antimycin a, an antibiotic with insecticidal and miticidal properties. Science 1950, 112, 172–173. [Google Scholar] [CrossRef] [PubMed]
- Hatanaka, H.; Iwami, M.; Kino, T.; Goto, T.; Okuhara, M. Fr-900520 and fr-900523, novel immunosuppressants isolated from a streptomyces. I. Taxonomy of the producing strain. J. Antibiot. (Tokyo) 1988, 41, 1586–1591. [Google Scholar] [CrossRef] [PubMed]
- Andexer, J.N.; Kendrew, S.G.; Nur-e-Alam, M.; Lazos, O.; Foster, T.A.; Zimmermann, A.S.; Warneck, T.D.; Suthar, D.; Coates, N.J.; Koehn, F.E.; et al. Biosynthesis of the immunosuppressants fk506, fk520, and rapamycin involves a previously undescribed family of enzymes acting on chorismate. Proc. Natl. Acad. Sci. USA 2011, 108, 4776–4781. [Google Scholar] [CrossRef]
- He, M.; Haltli, B.; Summers, M.; Feng, X.; Hucul, J. Isolation and characterization of meridamycin biosynthetic gene cluster from streptomyces sp. Nrrl 30748. Gene 2006, 377, 109–118. [Google Scholar] [CrossRef]
- Doscher, M.E.; Wood, I.B.; Pankavich, J.A.; Ricks, C.A. Efficacy of nemadectin, a new broad-spectrum endectocide, against natural infections of canine gastrointestinal helminths. Vet. Parasitol. 1989, 34, 255–259. [Google Scholar] [CrossRef]
- Seto, B. Rapamycin and mtor: A serendipitous discovery and implications for breast cancer. Clin. Transl. Med. 2012, 1, 29. [Google Scholar] [CrossRef]
- Rhodes, A.; Fantes, K.H.; Boothroyd, B.; McGonagle, M.P.; Crosse, R. Venturicidin: A new antifungal antibiotic of potential use in agriculture. Nature 1961, 192, 952–954. [Google Scholar] [CrossRef]
- Spizek, J.; Malek, I.; Suchy, J.; Vondracek, M.; Vanek, Z. Metabolites of streptomyces noursei. V. Relation of the production of cycloheximide and actiphenol to the production of fungicidin. Folia Microbiol. 1965, 10, 263–266. [Google Scholar]
- Seaton, P.J.; Gould, S.J. New products related to kinamycin from streptomyces murayamaensis. Ii. Structures of pre-kinamycin, keto-anhydrokinamycin, and kinamycins e and f. J. Antibiot. 1989, 42, 189–197. [Google Scholar] [CrossRef] [PubMed]
- Zhang, J.; Li, S.; Wu, X.; Guo, Z.; Lu, C.; Shen, Y. Nam7 hydroxylase is responsible for the formation of the naphthalenic ring in the biosynthesis of neoansamycins. Org. Lett. 2017, 19, 2442–2445. [Google Scholar] [CrossRef] [PubMed]
- Bhuyan, B.K.; Smith, C.G. Differential interaction of nogalamycin with DNA of varying base composition. Proc. Natl. Acad. Sci. USA 1965, 54, 566–572. [Google Scholar] [CrossRef] [PubMed]
- Koshino, H.; Takahashi, H.; Osada, H.; Isono, K. Reveromycins, new inhibitors of eukaryotic cell growth. Iii. Structures of reveromycins a, b, c and d. J. Antibiot. 1992, 45, 1420–1427. [Google Scholar] [CrossRef] [PubMed]
- Liu, W.; Nonaka, K.; Nie, L.; Zhang, J.; Christenson, S.D.; Bae, J.; Van Lanen, S.G.; Zazopoulos, E.; Farnet, C.M.; Yang, C.F.; et al. The neocarzinostatin biosynthetic gene cluster from streptomyces carzinostaticus atcc 15944 involving two iterative type i polyketide synthases. Chem. Biol. 2005, 12, 293–302. [Google Scholar] [CrossRef]
- BeBoer, C.; Dietz, A. The description and antibiotic production of streptomyces hygroscopicus var. Geldanus. J. Antibiot. 1976, 29, 1182–1188. [Google Scholar]
- Herbrik, A.; Corretto, E.; Chronakova, A.; Langhansova, H.; Petraskova, P.; Hrdy, J.; Cihak, M.; Kristufek, V.; Bobek, J.; Petricek, M.; et al. A human lung-associated streptomyces sp. Tr1341 produces various secondary metabolites responsible for virulence, cytotoxicity and modulation of immune response. Front. Microbiol. 2019, 10, 3028. [Google Scholar] [CrossRef]
- Knopik-Skrocka, A.; Bielawski, J. The mechanism of the hemolytic activity of polyene antibiotics. Cell Mol. Biol. Lett. 2002, 7, 31–48. [Google Scholar]
- te Welscher, Y.M.; Jones, L.; van Leeuwen, M.R.; Dijksterhuis, J.; de Kruijff, B.; Eitzen, G.; Breukink, E. Natamycin inhibits vacuole fusion at the priming phase via a specific interaction with ergosterol. Antimicrob. Agents Chemother. 2010, 54, 2618–2625. [Google Scholar] [CrossRef]
- Gray, K.C.; Palacios, D.S.; Dailey, I.; Endo, M.M.; Uno, B.E.; Wilcock, B.C.; Burke, M.D. Amphotericin primarily kills yeast by simply binding ergosterol. Proc. Natl. Acad. Sci. USA 2012, 109, 2234–2239. [Google Scholar] [CrossRef]
- Elliott, S.J.; Srinivas, S.; Albert, M.J.; Alam, K.; Robins-Browne, R.M.; Gunzburg, S.T.; Mee, B.J.; Chang, B.J. Characterization of the roles of hemolysin and other toxins in enteropathy caused by alpha-hemolytic escherichia coli linked to human diarrhea. Infect Immun. 1998, 66, 2040–2051. [Google Scholar] [CrossRef] [PubMed]
- Scherr, N.; Nguyen, L. Mycobacterium versus streptomyces--We are different, we are the same. Curr. Opin. Microbiol. 2009, 12, 699–707. [Google Scholar] [CrossRef] [PubMed]
- Wurzer, T. The Interaction of Streptomyces-like Bacteria and Model Microorganisms in Secondary Metabolite Production, Motility and Hemolytic Activities—Experimental. Bachelor’s Thesis, University of South Bohemia in České Budějovice, České Budějovice, Czech Republic, 2019. [Google Scholar]
- Labeda, D.P.; Goodfellow, M.; Brown, R.; Ward, A.C.; Lanoot, B.; Vanncanneyt, M.; Swings, J.; Kim, S.B.; Liu, Z.; Chun, J.; et al. Phylogenetic study of the species within the family streptomycetaceae. Antonie Van Leeuwenhoek 2012, 101, 73–104. [Google Scholar] [CrossRef] [PubMed]
- Rajesh, T.; Jeon, J.M.; Kim, Y.H.; Kim, H.J.; Yi da, H.; Park, S.H.; Choi, K.Y.; Kim, Y.G.; Kim, J.; Jung, S.; et al. Functional analysis of the gene sco1782 encoding streptomyces hemolysin (s-hemolysin) in streptomyces coelicolor m145. Toxicon 2013, 71, 159–165. [Google Scholar] [CrossRef] [PubMed]
- Harir, M.; Bendif, H.; Bellahcene, M.; Pogni, Z.F.R. Streptomyces secondary metabolites. In Basic Biology and Applications of Actinobacteria; Enany, S., Ed.; IntechOpen: London, UK, 2018. [Google Scholar]
- Bernal, M.G.; Campa-Cordova, A.I.; Saucedo, P.E.; Gonzalez, M.C.; Marrero, R.M.; Mazon-Suastegui, J.M. Isolation and in vitro selection of actinomycetes strains as potential probiotics for aquaculture. Vet. World 2015, 8, 170–176. [Google Scholar] [CrossRef]
- Sheng, Y.; Ou, Y.; Hu, X.; Deng, Z.; Bai, L.; Kang, Q. Generation of tetramycin b derivative with improved pharmacological property based on pathway engineering. Appl. Microbiol. Biotechnol. 2020, 104, 2561–2573. [Google Scholar] [CrossRef]
- Cinar, B.; Demir, Z.; Tunca, S. Heterologous expression of 8-demethyl-tetracenomycin (8-dmtc) affected streptomyces coelicolor life cycle. Braz. J. Microbiol. 2021, 52, 1107–1118. [Google Scholar] [CrossRef]
- Tenconi, E.; Traxler, M.F.; Hoebreck, C.; van Wezel, G.P.; Rigali, S. Production of prodiginines is part of a programmed cell death process in streptomyces coelicolor. Front. Microbiol. 2018, 9, 1742. [Google Scholar] [CrossRef]
- Haro-Reyes, T.; Diaz-Peralta, L.; Galvan-Hernandez, A.; Rodriguez-Lopez, A.; Rodriguez-Fragoso, L.; Ortega-Blake, I. Polyene antibiotics physical chemistry and their effect on lipid membranes; impacting biological processes and medical applications. Membranes 2022, 12, 681. [Google Scholar] [CrossRef]
- Grubbs, K.J.; Surup, F.; Biedermann, P.H.W.; McDonald, B.R.; Klassen, J.L.; Carlson, C.M.; Clardy, J.; Currie, C.R. Cycloheximide-producing streptomyces associated with xyleborinus saxesenii and xyleborus affinis fungus-farming ambrosia beetles. Front. Microbiol. 2020, 11, 562140. [Google Scholar] [CrossRef]
- Skelton, J.; Jusino, M.A.; Li, Y.; Bateman, C.; Thai, P.H.; Wu, C.; Lindner, D.L.; Hulcr, J. Detecting symbioses in complex communities: The fungal symbionts of bark and ambrosia beetles within asian pines. Microb. Ecol. 2018, 76, 839–850. [Google Scholar] [CrossRef] [PubMed]
- Goettler, W.; Kaltenpoth, M.; McDonald, S.; Strohm, E. Comparative morphology of the symbiont cultivation glands in the antennae of female digger wasps of the genus philanthus (hymenoptera: Crabronidae). Front. Physiol. 2022, 13, 815494. [Google Scholar] [CrossRef] [PubMed]
- Dhodary, B.; Spiteller, D. Ammonia production by streptomyces symbionts of acromyrmex leaf-cutting ants strongly inhibits the fungal pathogen escovopsis. Microorganisms 2021, 9, 1622. [Google Scholar] [CrossRef]
- Vergnes, S.; Gayrard, D.; Veyssière, M.; Toulotte, J.; Martinez, Y.; Dumont, V.; Bouchez, O.; Rey, T.; Dumas, B. Phyllosphere colonization by a soil streptomyces sp. Promotes plant defense responses against fungal infection. Mol. Plant-Microbe Interact. MPMI 2020, 33, 223–234. [Google Scholar] [CrossRef] [PubMed]
- Kim, D.R.; Cho, G.; Jeon, C.W.; Weller, D.M.; Thomashow, L.S.; Paulitz, T.C.; Kwak, Y.S. A mutualistic interaction between streptomyces bacteria, strawberry plants and pollinating bees. Nat. Commun. 2019, 10, 4802. [Google Scholar] [CrossRef] [PubMed]
- Dohet, L.; Grégoire, J.C.; Berasategui, A.; Kaltenpoth, M.; Biedermann, P.H. Bacterial and fungal symbionts of parasitic dendroctonus bark beetles. FEMS Microbiol. Ecol. 2016, 92. [Google Scholar] [CrossRef]
- Schlosser, E.; Gottlieb, D. Mode of hemolytic action of the antifungal polyene antibiotic filipin. Z. Naturforsch. B 1966, 21, 74–77. [Google Scholar] [CrossRef]
- Kim, J.D.; Han, J.W.; Lee, S.C.; Lee, D.; Hwang, I.C.; Kim, B.S. Disease control effect of strevertenes produced by streptomyces psammoticus against tomato fusarium wilt. J. Agric. Food Chem. 2011, 59, 1893–1899. [Google Scholar] [CrossRef]
- Shenin, Y.D.; Belakhov, V.V.; Araviiskii, R.A. Nystatin: Methods of preparation, search for derivatives, and prospects for medicinal use (review). Pharm. Chem. J. 1993, 27, 84–92. [Google Scholar] [CrossRef]
- Brautaset, T.; Bruheim, P.; Sletta, H.; Hagen, L.; Ellingsen, T.E.; Strom, A.R.; Valla, S.; Zotchev, S.B. Hexaene derivatives of nystatin produced as a result of an induced rearrangement within the nysc polyketide synthase gene in s. Noursei atcc 11455. Chem. Biol. 2002, 9, 367–373. [Google Scholar] [CrossRef]
- Asturias, J.A.; Liras, P.; Martin, J.F. Phosphate control of pabs gene transcription during candicidin biosynthesis. Gene 1990, 93, 79–84. [Google Scholar] [CrossRef] [PubMed]
- Szczeblewski, P.; Laskowski, T.; Kubacki, B.; Dziergowska, M.; Liczmanska, M.; Grynda, J.; Kubica, P.; Kot-Wasik, A.; Borowski, E. Analytical studies on ascosin, candicidin and levorin multicomponent antifungal antibiotic complexes. The stereostructure of ascosin a2. Sci. Rep. 2017, 7, 40158. [Google Scholar] [CrossRef] [PubMed]
- Brajtburg, J.; Medoff, G.; Kobayashi, G.S.; Elberg, S.; Finegold, C. Permeabilizing and hemolytic action of large and small polyene antibiotics on human erythrocytes. Antimicrob. Agents Chemother. 1980, 18, 586–592. [Google Scholar] [CrossRef] [PubMed]
- Hammond, S.M.; Kliger, B.N. Mode of action of the polyene antibiotic candicidin: Binding factors in the wall of candida albicans. Antimicrob. Agents Chemother. 1976, 9, 561–568. [Google Scholar] [CrossRef] [PubMed][Green Version]
- Mikulik, K.; Bobek, J.; Zidkova, J.; Felsberg, J. 6s rna modulates growth and antibiotic production in streptomyces coelicolor. Appl. Microbiol. Biotechnol. 2014, 98, 7185–7197. [Google Scholar] [CrossRef]
- Bobek, J.; Strakova, E.; Zikova, A.; Vohradsky, J. Changes in activity of metabolic and regulatory pathways during germination of s. Coelicolor. BMC Genom. 2014, 15, 1173. [Google Scholar] [CrossRef][Green Version]
- Mikulik, K.; Suchan, P.; Bobek, J. Changes in ribosome function induced by protein kinase associated with ribosomes of streptomyces collinus producing kirromycin. Biochem. Biophys. Res. Commun. 2001, 289, 434–443. [Google Scholar] [CrossRef]
- Horinouchi, S. A microbial hormone, a-factor, as a master switch for morphological differentiation and secondary metabolism in streptomyces griseus. Front. Biosci. 2002, 7, d2045–d2057. [Google Scholar]
- Takano, E. Gamma-butyrolactones: Streptomyces signalling molecules regulating antibiotic production and differentiation. Curr. Opin. Microbiol. 2006, 9, 287–294. [Google Scholar] [CrossRef]
- Yamanaka, K.; Oikawa, H.; Ogawa, H.O.; Hosono, K.; Shinmachi, F.; Takano, H.; Sakuda, S.; Beppu, T.; Ueda, K. Desferrioxamine e produced by streptomyces griseus stimulates growth and development of streptomyces tanashiensis. Microbiology (Reading) 2005, 151, 2899–2905. [Google Scholar] [CrossRef]
- Lee, H.J.; Whang, K.S. Streptomyces rhizosphaerihabitans sp. Nov. And streptomyces adustus sp. Nov., isolated from bamboo forest soil. Int. J. Syst. Evol. Microbiol. 2016, 66, 3573–3578. [Google Scholar] [CrossRef] [PubMed]
- Human, Z.R.; Moon, K.; Bae, M.; de Beer, Z.W.; Cha, S.; Wingfield, M.J.; Slippers, B.; Oh, D.C.; Venter, S.N. Antifungal streptomyces spp. Associated with the infructescences of protea spp. In south africa. Front. Microbiol. 2016, 7, 1657. [Google Scholar] [CrossRef] [PubMed]
- Shirling, E.B.; Gottlieb, D. Methods for characterization of streptomyces species1. Int. J. Syst. Evol. Microbiol. 1966, 16, 313–340. [Google Scholar]
- Chun, J.; Oren, A.; Ventosa, A.; Christensen, H.; Arahal, D.R.; da Costa, M.S.; Rooney, A.P.; Yi, H.; Xu, X.-W.; De Meyer, S.; et al. Proposed minimal standards for the use of genome data for the taxonomy of prokaryotes. Int. J. Syst. Evol. Microbiol. 2018, 68, 461–466. [Google Scholar] [CrossRef]
- Kotrbová, L.; Lara, A.C.; Corretto, E.; Scharfen, J.; Ulmann, V.; Petříčková, K.; Chroňáková, A. Evaluation and comparison of antibiotic susceptibility profiles of streptomyces spp. From clinical specimens revealed common and region-dependent resistance patterns. Sci. Rep. 2022, 12, 1–12. [Google Scholar] [CrossRef]
- Chun, J.; Lee, J.H.; Jung, Y.; Kim, M.; Kim, S.; Kim, B.K.; Lim, Y.W. Eztaxon: A web-based tool for the identification of prokaryotes based on 16s ribosomal rna gene sequences. Int. J. Syst. Evol. Microbiol. 2007, 57, 2259–2261. [Google Scholar] [CrossRef] [PubMed]
- Schoch, C.L.; Ciufo, S.; Domrachev, M.; Hotton, C.L.; Kannan, S.; Khovanskaya, R.; Leipe, D.; McVeigh, R.; O’Neill, K.; Robbertse, B.; et al. Ncbi taxonomy: A comprehensive update on curation, resources and tools. Database 2020, 2020, baaa062. [Google Scholar] [CrossRef]
- Edgar, R.C. Muscle: A multiple sequence alignment method with reduced time and space complexity. BMC Bioinform. 2004, 5, 113. [Google Scholar] [CrossRef]
- Stamatakis, A. Raxml version 8: A tool for phylogenetic analysis and post-analysis of large phylogenies. Bioinformatics 2014, 30, 1312–1313. [Google Scholar] [CrossRef]
- Letunic, I.; Bork, P. Interactive tree of life (itol) v5: An online tool for phylogenetic tree display and annotation. Nucleic Acids Res. 2021, 49, W293–W296. [Google Scholar] [CrossRef]
- Ochi, K. Metabolic initiation of differentiation and secondary metabolism by streptomyces griseus: Significance of the stringent response (ppgpp) and gtp content in relation to a factor. J. Bacteriol. 1987, 169, 3608–3616. [Google Scholar] [CrossRef] [PubMed]
- Kamenik, Z.; Hadacek, F.; Mareckova, M.; Ulanova, D.; Kopecky, J.; Chobot, V.; Plhackova, K.; Olsovska, J. Ultra-high-performance liquid chromatography fingerprinting method for chemical screening of metabolites in cultivation broth. J. Chromatogr. A 2010, 1217, 8016–8025. [Google Scholar] [CrossRef] [PubMed]
- Cihak, M.; Kamenik, Z.; Smidova, K.; Bergman, N.; Benada, O.; Kofronova, O.; Petrickova, K.; Bobek, J. Secondary metabolites produced during the germination of streptomyces coelicolor. Front. Microbiol. 2017, 8, 2495. [Google Scholar] [CrossRef]
- Guan, S.; Ji, C.; Zhou, T.; Li, J.; Ma, Q.; Niu, T. Aflatoxin b(1) degradation by stenotrophomonas maltophilia and other microbes selected using coumarin medium. Int. J. Mol. Sci. 2008, 9, 1489–1503. [Google Scholar] [CrossRef] [PubMed]

| Compound | Formula | Calculated Average Mass | Activities | Ref. | ||||
|---|---|---|---|---|---|---|---|---|
| CYCLIC—TETRAENES | AB | AF | AP/I | HL/CL | AC | |||
| Amphotericin A * | C47H75NO17 | 926.1090 | + | + | [13] | |||
| Antifungalmycin 702 | C35H60O14 | 704.8530 | + | [14] | ||||
| Arenomycin B (Lucensomycin) | C36H55NO13 | 709.8316 | + | [15] | ||||
| Aureofuscin | C28H43NO12 | 585.6490 | + | [16] | ||||
| Lucimycin (Lucensomycin, Etruscomycin) | C36H53NO13 | 707.8158 | + | + | [17] | |||
| NPP A1 | C55H88N2O22 | 1129.3040 | + | [18] | ||||
| Nystatin A1 (Fungicidin) * | C47H75NO17 | 926.1090 | - | + | [19] | |||
| Nystatin A2 | C47H75NO16 | 910.1096 | ||||||
| Nystatin A3 | C53H85NO20 | 1056.2526 | ||||||
| Pimaricin (Natamycin) */** | C33H47NO13 | 665.7351 | + | - | [20] | |||
| Polyfungin B | C53H85NO19 | 1040.2532 | + | [21] | ||||
| Protocidin | C29H45NO13 | 615.6752 | [22] | |||||
| Rimocidin | C39H61NO14 | 767.9117 | - | + | [23] | |||
| Tetrafungin | C47H82NO23 | 1029.1610 | + | [24] | ||||
| Tetramycin A Tetramycin B | C35H53NO13 C35H53NO14 | 695.8048 711.8042 | + | + | [25] | |||
| Tetrin A Tetrin B Tetrin C | C34H51NO13 C34H51NO14 C34H49NO13 | 681.7779 697.7773 679.7620 | + | [26] | ||||
| [27] | ||||||||
| Toyamycin (Akitamycin) | C41H65NO18 | 859.9630 | + | [28] | ||||
| PA-166 | C35H53NO14 | 711.8042 | + | [28] | ||||
| CYCLIC—PENTAENES | AB | AF | AP/I | HL/CL | AC | |||
| Aurenin (1’-Hydroxyisochainin) | C33H54O11 | 626.7852 | + | [29] | ||||
| Capacidin | C54H85NO18 | 1050.2716 | + | [30] | ||||
| Chainin | C33H54O10 | 610.7858 | + | [31] | ||||
| Elizabethin | C35H58O12 | 670.8383 | + | [32] | ||||
| Filipin I | C35H58O9 | 622.8401 | + | + | [33] | |||
| Filipin II | C35H58O10 | 638.8395 | ||||||
| Filipin III | C35H58O11 | 654.8389 | ||||||
| Filipin IV | C35H58O11 | 654.8389 | ||||||
| Fungichromin (Pentamycin) * | C35H58O12 | 670.8383 | + | + | + | [34] | ||
| Homochainin | C34H56O10 | 624.8126 | + | [31] | ||||
| Isochainin | C33H54O10 | 610.7858 | + | [35] | ||||
| Kabicidin | C35H60O13 | 688.8536 | + | [36] | ||||
| Lienomycin | C67H107NO18 | 1214.5825 | + | + | + | [37] | ||
| Moldicidin A | C42H81NO19 | 904.1005 | + | [16] | ||||
| Norchainin | C32H52O10 | 596.7589 | + | [31] | ||||
| Onomycin-I Onomycin-II | C43H76NO17 C42H67NO17 | 879.0730 857.9905 | + | [38] | ||||
| Pentacidin | C31H50O10 | 582.7320 | + | [16] | ||||
| Pentafungin | C41H74NO16 | 837.0357 | + | [39] | ||||
| PA-153 | C37H61NO14 | 743.8897 | + | [28] | ||||
| S 728 | C56H93NO20 | 1100.3492 | + | [16] | ||||
| Reedsmycin A-E Reedsmycin F | C36H58O10 C36H58O11 | 650.8505 666.8499 | + | [40] | ||||
| Selvamicin | C47H76O18 | 929,0955 | + | [41] | ||||
| Strevertene A Strevertene B Strevertene C Strevertene D Strevertene E Strevertene F Strevertene G | C31H48O10 C32H50O10 C32H50O10 C33H52O10 C33H52O10 C34H54O10 C31H50O9 | 580.7161 594.7430 594.7430 608.7699 608.7699 622.7968 566.7326 | + | [42] | ||||
| Takanawaene A Takanawaene B Takanawaene C | C30H48O8 C32H52O8 C33H51O8 | 536.7063 564.7601 578.7870 | + | [43] | ||||
| Thailandin A Thailandin B | C39H62O14 C33H52O10 | 754.9208 608.7699 | + | [44] | ||||
| CYCLIC—HEXAENES | AB | AF | AP/I | HL/CL | AC | |||
| Candihexin A | C48H76NO19/C43H76NO19/C43H77NO19 | 971.1268/911.0718/912.0797 | + | [45] | ||||
| Candihexin B | C48H90NO21/C48H91NO21 | 1017.2367/1018.2447 | + | [45] | ||||
| Candihexin E | C38H67NO16 | 793.9471 | + | [45] | ||||
| Cryptocidin | C52H84NO17 | 995.2355 | + | + | [46] | |||
| Grecomycin | C38H41O10/C38H38O10 | 657.7375/654.712 | + | + | [47] | |||
| CYCLIC—HEPTAENES | AB | AF | AP/I | HL/CL | AC | |||
| Acmycin | C36H68NO30 | 994.9247 | + | [48] | ||||
| Amphotericin B | C47H73NO17 | 924.0932 | + | + | [49] | |||
| Aureofungin A | C59H86N2O19/C59H88N2O19 | 1127.3339/1129.3498 | + | [50] | ||||
| Aureofungin B | C57H85NO19/C57H87NO19 | 1088.2972/1090.3131 | + | [50] | ||||
| Candicidin A1 (VI, Levorin A0, Ascosin A1) * Candicidin A2 (D, A, D1, Levorin A2, Ascosin A2) Candicidin A3 (V, Levorin A3, Ascosin A3) | C59H84N2O17 C59H84N2O18 C59H86N2O18 | 1093.3272 1109.3186 1111.3345 | + | + | [51] | |||
| Candidin | C47H71NO17 | 922.0773 | + | [52] | ||||
| Flavumycin A | C60H91N2O17/C54H79NO16 | 1112.3858/998.2184 | + | [53] | ||||
| Fungimycin | C59H86N2O17 | 1095.3351 | + | + | + | [54] | ||
| Hamycin A | C58H86N2O19 | 1115.3229 | + | + | + | [55] | ||
| Isolevorin A2 | C60H86N2O18 | 1123.3455 | + | [56] | ||||
| Levorin A2 | C59H86N2O18/C59H89N2O18 | 1111.3345/1114.3583 | + | [57] | ||||
| Levorin B | C62H98N2O25 | 1271.4586 | + | [58] | ||||
| Lucknomycin | C61H98N2O24/C54H80N2O19 | 1243.4482/1061.2313 | + | [59] | ||||
| Partricin A | C59H86N2O9 | 967.3399 | + | [60] | ||||
| Partricin B | C55H84N2O19 | 1077.2740 | + | [60] | ||||
| Perimycin A | C59H88N2O17 | 1097.3510 | + | [61] | ||||
| Trichomycin A | C58H84N2O18/C61H86N2O21 | 1097.3076/1183.3547 | + | + | [62] | |||
| AF-1231 | C42H68N2O17 | 873.0052 | + | [16] | ||||
| DJ-400 B1 DJ-400 B2 | C65H96N2O21 C58H86N2O20 | 1241.4781 1131.3223 | + | [38] | ||||
| 67-121 A 67-121 C | C59H88N2O19 C65H98N2O28 | 1129.3498 1355.4898 | + | [38] | ||||
| NPP B1 | C55H86N2O22 | 1127.2881 | + | [18] | ||||
| LINEAR POLYENES | AB | AF | AP/I | HL/CL | AC | |||
| AB023a AB023b | C31H50O8 C32H52O8 | 550.7332 564.7601 | + | [63] | ||||
| Clethramycin | C63H99N3O18S | 1218.5545 | + | [64] | ||||
| ECO-02301 | C70H109N2O20 | 1298.6369 | + | [65] | ||||
| Etnangien | C49H76O11 | 841.1358 | + | [66] | ||||
| Linearmycin A Linearmycin B Linearmycin C | C64H101NO16 C66H103NO16 C67H105NO16 | 1140.5031 1166.5410 1180.5678 | + | + | + | [67] | ||
| Mediomycin Mediomycin A Mediomycin B | C62H99NO16S C62H97NO18S C62H97NO15 | 1146.5312 1176.5141 1096.4499 | + | [64] | ||||
| Meijiemycin | C66H105NO19 | 1216.5550 | + | [68] | ||||
| Mycangimycin | C20H24O4 | 328.4082 | + | [69] | ||||
| Neotetrafibricin A | C67H105NO19 | 1228.5660 | + | [64] | ||||
| Compound | Formula | Calculated Average Mass | Activities | Ref. |
|---|---|---|---|---|
| PEPTIDES | ||||
| Surugamide A | C48H81N9O8 | 912.21428 | anticancer, antifungal | [70] |
| Polyoxypeptin | C35H60O14 | 704.84403 | pro-apoptotic | [71] |
| Bleomycin | C55H84N17O21S3+ | 1415.55415 | anti-cancer | [72] |
| Actinomycin D | C62H86N12O16 | 1255.41969 | anti-cancer | [73] |
| Mirubactin | C26H32N6O11 | 604.56701 | siderophore | [74] |
| ANTIMYCINS | ||||
| Antimycin A | C24H40N2O9 | 548.62641 | inhibitor of respiration | [75] |
| NON-POLYENIC MACROLIDES | ||||
| FK506 (Tacrolimus) | C44H69NO12 | 804.02005 | immunosuppressive, antifungal | [76] |
| FK520 (Ascomycin) | C43H69NO12 | 792.00931 | immunosuppressive, antifungal | [77] |
| Meridamycin | C45H75NO12 | 822.07844 | neuroprotective | [78] |
| Nemadectin | C36H52O8 | 612.79481 | antiparasitic | [79] |
| Sirolimus (Rapamycin)–a cyclic molecule containing conjugated triene. | C51H79NO13 | 914.17404 | immunosuppressive, antifungal | [80] |
| Venturicidin B | C40H66O10 | 706.94776 | antifungal | [81] |
| NON-POLYENIC POLYKETIDES | ||||
| Actiphenol | C15H17NO4 | 275.30042 | proteosynthesis inhibitor | [82] |
| Kinamycin F | C18H14N2O7 | 370.31373 | anti-cancer | [83] |
| Neoansamycin A | C30H37NO7 | 523.61855 | antibiotic, antiviral | [84] |
| Nogalamycin | C39H49NO16 | 787.80515 | anti-cancer | [85] |
| Reveromycin A | C36H52O11 | 660.79303 | EGF inhibitor | [86] |
| OTHER—ACTIVE ON THE HUMAN CELLS | ||||
| Neocarzinostatin | C35H33NO12 | 659.63751 | anti-cancer | [87] |
| Nocardamine | C27H48N6O9 | 600.70599 | anti-cancer siderophore | [88] |
| BCCO Strain No. | Metabolite Produced | Streptomyces sp. (Vertical Line) Candida albicans (Horizontal Line) | Size of Inhibitory Zone (mm) | Size of Hemolytic Zone (mm) |
|---|---|---|---|---|
| 10_1099 | candicidin A, A1, A3; surugamide A | ![]() | 10 | 7 |
| 10_1093 | tetrafungin, tetrin A, polyene B | ![]() | 5 | 9 |
| 10_1094 | tetrafungin, tetrin A, polyene B | ![]() | 3 | 9 |
| 10_1095 | tetrafungin, tetrin A, polyene B | ![]() | 3 | 7 |
| 10_1104 | tetrafungin, tetrin A, polyene B | ![]() | 8 | 8 |
| 10_2282 | tetrafungin, tetrin A, polyene B | ![]() | 12 | 16 |
| BCCO Strain No./Found Metabolite | Paecilomyces spp. | Fusarium spp. | Aspergillus fumigatus | Aspergillus niger | Cultivation Timing/Streptomycete Hemolysis |
|---|---|---|---|---|---|
| 10_2259 | 6 | 0 | 0 | 0 | Streptomyces 144 h; fungus 72 h |
| actiphenol (?) | ![]() | ![]() | ![]() | ![]() | ![]() |
| 10_1099 | 10 | no growth | 0 | 6 | Streptomyces 96 h; fungus 72h |
| candicidin | ![]() | ![]() | ![]() | ![]() | ![]() |
| 10_1106 | 8 | 0 | 0 | 2 | Streptomyces 96 h; fungus 72 h |
| polyene A | ![]() | ![]() | ![]() | ![]() | ![]() |
| 10_1092 | 11 | no growth | 3 | 8 | Streptomyces 144 h; fungus 72 h |
| tetrafungin, tetrin A, polyene B | ![]() | ![]() | ![]() | ![]() | ![]() |
| 10_1093 | 8 | no growth | 1 | 6 | Streptomyces 96 h; fungus 72 h |
| tetrafungin, tetrin A, polyene B | ![]() | ![]() | ![]() | ![]() | ![]() |
| 10_1094 | 20 | no growth | 1 | 5 | Streptomyces 96 h; fungus 72 h |
| tetrafungin, tetrin A, polyene B | ![]() | ![]() | ![]() | ![]() | ![]() |
| 10_1095 | 5 | 0 | 0 | 4 | Streptomyces 96 h; fungus 72 h |
| tetrafungin, tetrin A, polyene B | ![]() | ![]() | ![]() | ![]() | ![]() |
| 10_1097 | 12 | 0 | 0 | 9 | Streptomyces 96 h; fungus 72 h |
| polyene B | ![]() | ![]() | ![]() | ![]() | ![]() |
| 10_1104 | 24 | 3 | 3 | 16 | Streptomyces 144 h; fungus 72 h |
| tetrafungin, tetrin A, polyene B | ![]() | ![]() | ![]() | ![]() | ![]() |
| 10_2282 | 20 | 0 | 0 | 6 | Streptomyces 144 h; fungus 72 h |
| tetrafungin, tetrin A, polyene B | ![]() | ![]() | ![]() | ![]() | ![]() |
| 10_2389 | no growth | 0 | 0 | 12 | Streptomyces 144 h; fungus 72 h |
| polyene B | ![]() | ![]() | ![]() | ![]() | ![]() |
| 10_2309 | 24 | 0 | 0 | 4 | Streptomyces 144 h; fungus 72 h |
| polyene C (?) | ![]() | ![]() | ![]() | ![]() | ![]() |
Publisher’s Note: MDPI stays neutral with regard to jurisdictional claims in published maps and institutional affiliations. |
© 2022 by the authors. Licensee MDPI, Basel, Switzerland. This article is an open access article distributed under the terms and conditions of the Creative Commons Attribution (CC BY) license (https://creativecommons.org/licenses/by/4.0/).
Share and Cite
Bobek, J.; Filipová, E.; Bergman, N.; Čihák, M.; Petříček, M.; Lara, A.C.; Kristufek, V.; Megyes, M.; Wurzer, T.; Chroňáková, A.; et al. Polyenic Antibiotics and Other Antifungal Compounds Produced by Hemolytic Streptomyces Species. Int. J. Mol. Sci. 2022, 23, 15045. https://doi.org/10.3390/ijms232315045
Bobek J, Filipová E, Bergman N, Čihák M, Petříček M, Lara AC, Kristufek V, Megyes M, Wurzer T, Chroňáková A, et al. Polyenic Antibiotics and Other Antifungal Compounds Produced by Hemolytic Streptomyces Species. International Journal of Molecular Sciences. 2022; 23(23):15045. https://doi.org/10.3390/ijms232315045
Chicago/Turabian StyleBobek, Jan, Eliška Filipová, Natalie Bergman, Matouš Čihák, Miroslav Petříček, Ana Catalina Lara, Vaclav Kristufek, Melinda Megyes, Theresa Wurzer, Alica Chroňáková, and et al. 2022. "Polyenic Antibiotics and Other Antifungal Compounds Produced by Hemolytic Streptomyces Species" International Journal of Molecular Sciences 23, no. 23: 15045. https://doi.org/10.3390/ijms232315045
APA StyleBobek, J., Filipová, E., Bergman, N., Čihák, M., Petříček, M., Lara, A. C., Kristufek, V., Megyes, M., Wurzer, T., Chroňáková, A., & Petříčková, K. (2022). Polyenic Antibiotics and Other Antifungal Compounds Produced by Hemolytic Streptomyces Species. International Journal of Molecular Sciences, 23(23), 15045. https://doi.org/10.3390/ijms232315045